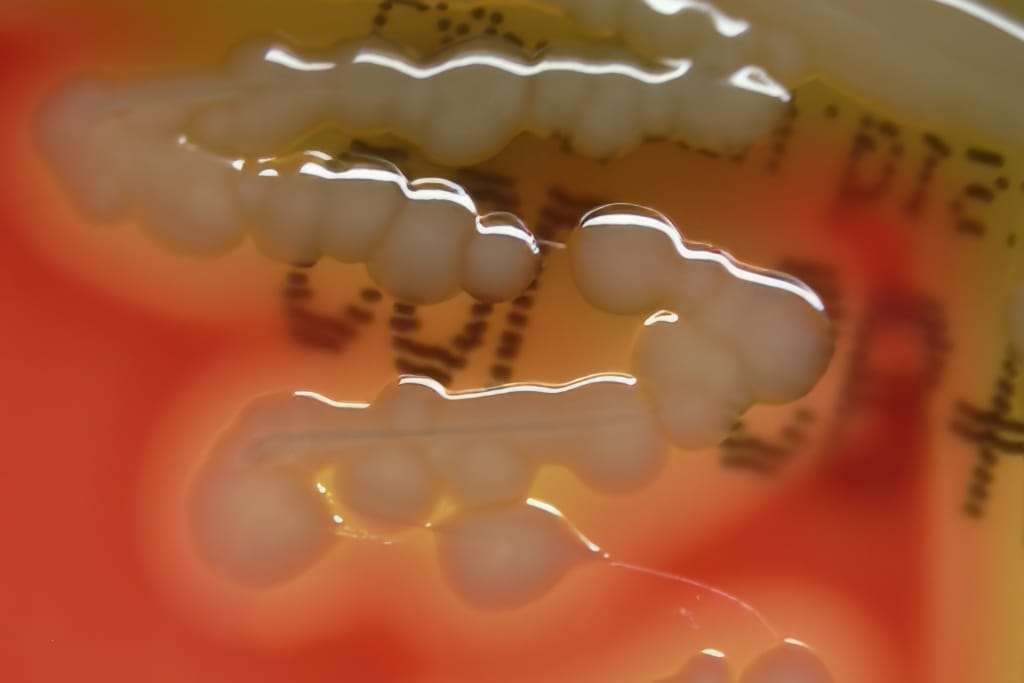
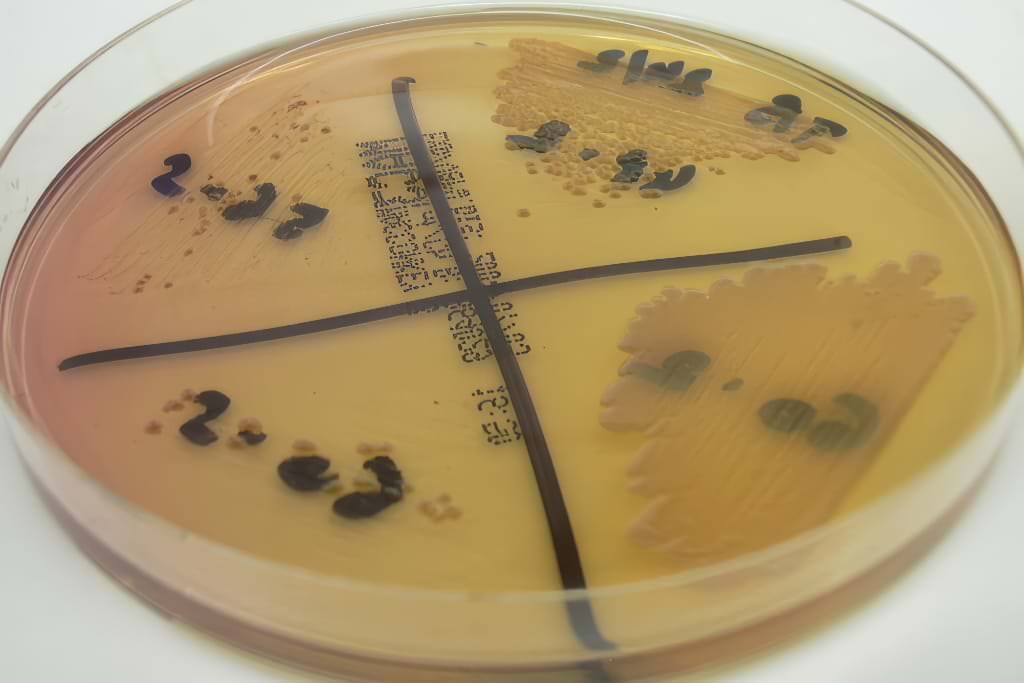

Om verder te bouwen op mijn artikel bacteriële huidziekten bij vissen de theorie kom ik u met dit schrijven iets meer vertellen over de Aeromonas/Pseudomonas bacteriën zelf, het ziekteverloop en de diagnose van huidinfecties. Wat er zoal aan gedaan kan worden (preventief/curatief) en iets over de prognose is voor een volgend artikel.
De kwelgeesten
Zowel Aeromonas als Pseudomonas bacteriën behoren tot de groep der Vibrionaceae. Binnen hun groep is verdere opsplitsing zeer complex. Aeromonas kiemen kunnen meestal groeien bij 37°C, de temperatuur die in labo”s standaard gebruikt wordt voor bacteriologisch onderzoek van zoogdieren. Deze, we noemen ze mesofiele Aeromonas species, kennen we vooral onder de naam A. Hydrophila maar eigenlijk zijn er al minstens 14 soorten van bekend die desondanks als vispathogeen steeds A. Hydrophila of A. Sobria benoemd worden. Een gevreesde Aeromonas is de A. Salmonicida, deze wil niet groeien bij 37°C wat zijn verwantschap met visziekten al meer benadrukt, we noemen ze psychrofiel. Ook Pseudomonas Fluorescens, de belangrijkste koipathogene Pseudomonas, wil niet of maar heel traag groeien bij 37°C. Bij 4°C groeien bovenvermelde A./P. soorten gewoon door, wel aan een iets trager tempo. Het zijn allen gram-negatieve kiemen en vormen geen sporen.
Iets over het ziekteverloop
In veel gevallen is de betrokkenheid van bacteriën bij een aandoening vrij duidelijk op te merken. Weefsel is weggevreten, open wonden, tekenen van septicaemie,.. Veel mensen vragen zich dan af waaraan hun koi zich zodanig kan beschadigd hebben maar meestal begint dit met een klein defect bijvoorbeeld een ontstoken schub die ondermijnd wordt door ziekteverwekkende bacteriën (die zijn in elke vijver toch zowieso aanwezig), gaat opzetten en op korte tot middellange termijn krijg je een lelijke geïnfecteerde wonde met uitval van schubben. Wanneer dit zich op de rug van de koi bevind krijg je het snel in de gaten maar infecties van de muil of buik worden veelal pas heel laat opgemerkt. Zeker in zulke gevallen neemt het aantal ziekteverwekkers in de vijver sterk toe : de hele beschadigde zone van de vis gaat dienst doen als feestmaal voor de bacteriën waardoor die zich in overvloed vermeerderen. Aldus neemt de infectie-druk in de vijver sterk toe en kunnen meerdere vissen bacterieel ziek worden.

In weinig gevallen zijn de bacteriën echter dermate virulent dat ze op zichzelf de infectie initieel kunnen aangewoekerd hebben. Daarom is het altijd van cruciaal belang om na te gaan welke andere factoren van negatieve invloed kunnen geweest zijn bij zulk een ziektegeval en is het essentieel om de waterkwaliteit en aanwezigheid van parasieten op zijn minst ook na te gaan. Om (nog) maar eens in herhaling te vallen.. Aeromonas/Pseudomonas zijn zowieso in elke vijver aanwezig en wachten op een zwak moment van de koi om te kunnen aanvallen. Een vroege diagnose en behandeling (indien nodig) is belangrijk opdat het aantal ziekteverwekkers niet drastisch gaat stijgen en geen bijkomende slachtoffers gaat maken.

In de meeste gevallen gaat een infectie van buitenaf naar binnen de vis dringen. Soms echter kunnen de kiemen van binnenin naar buiten toe werken wat de prognose voor de vis niet ten goede komt. Als de bacterie zich in het lichaam gaat spreiden krijg je aantasting van verschillende organen met functieverlies, in dit geval kan je symptomen zien als buikwaterzucht en uitpuilende ogen. Als een geïnfecteerde wonde van de huid afgesloten raakt van de buitenwereld kan zich een abces vormen waarin een veelheid aan etter gevormd wordt, veelal bezoedeld met bacteriën van het genus Serratia.
In de zomer merk ik eerder infecties op waar Aeromonas overheersend is terwijl in de winter Pseudomonas Fluorescens vaker voor problemen zorgt. Zelfs bij een watertemperatuur van 4 tot 6°C trof ik deze laatste al enkele malen aan onder de vorm van een acute spreidende kieuwinfectie met sterfte.

Wat zie je
De mensen zelf zeggen meestal dat hun vis zich beschadigd heeft, open wonden of beschadigde vinnen heeft. Elke abnormale roodheid is verdacht, dit wijst meestal op ontsteking, wat niet wil zeggen dat er infectie mee gemoeid is!
Als dierenarts kijk je met een geoefend oog vooral naar het aspect van de wonde, de plaats, aantal vissen met symptomen, de relatie met andere factoren, ..
Bijvoorbeeld : een wonde kan sterk lokaal zijn en open, in dat geval is de term ulceratie (verzwering) op zijn plaats. Wanneer een infectie diffuser is, onder de schubben door loopt en dus niet scherp afgelijnd is benoem ik het liever als erythrodermatitis. In de literatuur gebruikt men beide termen veelal samen of door elkaar. Ulceratie komt vaak voor aan de snuit, de flank en aan de staart. Erythrodermatitis is eerder ter hoogte van de flank. Beide termen zeggen dus vooral iets over het aspect van de infectie. In zowat de helft of meer van de gevallen zijn de vinnen betrokken in het ziekteproces (vinrot).

Niet al wat rood en eventueel ontstoken is, is dus bacterieel geïnfecteerd. Soms is de rug van koi massaal besmet met huidwormen maar krijg je visueel het idee dat er iets ernstiger aan de hand is, soms heeft de koi effectief een schaafwonde opgelopen. In het eerste geval is een injectie met een wormdodend middel (of waterbehandeling voor een groep vissen) meestal afdoende, in het tweede geval de wonde lokaal behandelen met een ontsmettend en beschermend product.
Soms wordt de wonde overgroeid met algen en/of schimmels en zie je enkel een groene of witte ietwat pluizige waas lokaal op de vis. Schimmels en algen zijn in elke vijver aanwezig en profiteren van de huid van de vis die geen verweer meer kan bieden tegen hun invloed (afwezig zijn van slijm). Een persisterende schimmelinfectie over een grote huidwonde duidt er wel eens op dat er over de wonde zelf een stuk dode huid zit die dan verwijderd dient te worden.

Bij geschubde vissen kan bij een ernstige ontsteking (meestal met infectie) ontstekingsvocht in de schubzakjes ophopen waardoor de schubben recht komen te staan. Bij het uitoefenen van enige druk komt er dan behoorlijk wat vocht vrij.

Soms wordt een hele zone van de geïnfecteerde huid ondermijnd, hier kunnen bovendien bloedingen ontstaan en op die manier gaat de vis veel vocht opnemen, zouten verliezen en bloedarmoede krijgen als er niet tijdig ingegrepen wordt.

Diagnose
Onmisbaar in het stellen van een definitieve diagnose, en als aanloop naar het bieden van de best mogelijke behandeling, is het isoleren van de betrokken bacterië(n), zijn soort bepalen of inschatten en het aanleggen van een antibiogram. Hiervoor wordt er door de dierenarts een staaltje genomen en later door hem of door een ervaren labo verder onderzocht.
Op een geïnfecteerde haard zitten duizenden bacteriën, maar omdat de meeste (ziekteverwekkende) kiemen met de microscoop er niet anders uitzien dan een heel klein bolletje of staafje (en dit al bij een vergroting van 1000x), kan je op die manier niets zeggen over de bacteriesoort. Daarom moet je ze laten vermeerderen totdat je zichtbare en zuivere kolonies krijgt, hiermee kan je verder werken.
Ook hier is ervaring en kennis essentieel. Het is weinig zinvol een staal voor kweek te nemen van een oude overwoekerde wonde, of van een plaats waar de bacteriën uitgeleefd zijn om het zo te stellen, je moet ze vatten op hun meest actieve plaats en moment. Met een swap, een soort van oorstokje dat geheel steriel in een omhulsel bewaard wordt, kan de gekozen geïnfecteerde zone bestreken worden. Wanneer het op cultuur brengen hiervan vrijwel onmiddellijk zal plaats vinden hoeft de swab niet op transportmedium gehouden te worden, anders wel. Hierin zitten de bacteriën veilig, vrij van contaminatie en hebben ze voeding om in leven te blijven maar niet om al volop te gaan groeien. Ze worden dan koel bewaard en zo snel mogelijk verder onderzocht. De werkdag van een koidokter zit er dan ook nog niet op bij thuiskomst s”avonds (laat).
Voor het uitenten en dus op kweek brengen van de kiemen zijn diverse voedingsbodems beschikbaar. Hier is persoonlijke ervaring vooral doorslaggevend naar de keuze. Je gaat immers vaak omgevingsbacteriën mee opkweken (bijvoorbeeld Shewanella, Alcaligenes) en die heb je uiteraard niet nodig. Selectievere media kunnen een deel van die flora uitdunnen maar soms groeit dan ook de ziekteverwekker zelf niet meer.. Sommige Aeromonas groeien bijvoorbeeld niet op MacConkey agar (een soort van voedingsbodem).
Na 24u zijn de kiemen uitgegroeid tot zichtbare kolonies.
Op basis van diens uitzicht (macroscopisch en microscopisch), beweeglijkheid, geur, groeivoorkeur op diverse voedingsbodems krijgt men bijvoorbeeld al een goed idee over met welke kiem je te maken hebt. Verdere bijkomende testjes kunnen dat vermoeden bevestigen of ontkennen (bvb. oxidase, kligler). In geval van twijfel wordt, en indien nodig, het labo ingeschakeld die met meer testen naar biochemische karakteristieken een identificatie kunnen doen. In de toekomst zal rechtstreekse DNA-identificatie belangrijker worden.

Typisch voor bacteriën van het genus Aeromonas en Pseudomonas is dat ze ongevoelig zijn voor een bepaalde stof, het vibriostaticum O/129 genaamd. Dit zou dus kunnen dienen om te bepalen of een gekweekte bacterie tot deze groep kan behoren. Toch duikt soms een Aeromonas of Pseudomonas op die O/129-gevoelig is wat dit als diagnostisch criterium in een twijfelachtige situatie brengt.
Zelden haal je slechts 1 bacteriesoort uit een wonde (een zogenaamde reincultuur, dit zou het beste geval zijn), vaak komen Aeromonas en Pseudomonas naast elkaar voor, soms zie je zelfs 2 soorten Aeromonas of 2 soorten Pseudomonas opduiken uit één staal. Een bacterie opkweken is vrij eenvoudig, het interpreteren van het resultaat en uitzuiveren van de oorzakelijke kiem(en) daarentegen is specialistenwerk! Een Shewanella, Alcaligenes of andere kiem kunnen immers qua uitzicht en eigenschappen sterk gelijkend zijn met de Aermonas/Pseudomonas soorten waardoor verwarring snel gebeurd is.



